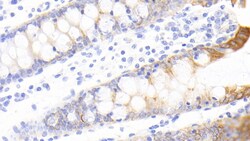
Invitrogen FAM5C Polyclonal Antibody 200 &mu;L; Unconjugated:Antibodies,

missing translation for 'onlineSavingsMsg'
Learn More
Learn More
Invitrogen™ FAM5C Polyclonal Antibody


Rabbit Polyclonal Antibody
Supplier: Invitrogen™ PA5150005
Description
FAM5C Polyclonal Antibody for Western Blot, ICC/IF, IHC (P)
Inhibits neuronal cell proliferation by negative regulation of the cell cycle transition. Promotes pituitary gonadotrope cell proliferation, migration and invasion, when overexpressed. May play a role in cell pituitary tumor development.Identifiants chimiques
| FAM5C | |
| Store at 4°C short term. For long term storage, store at -20°C, avoiding freeze/thaw cycles. | |
| Polyclonal | |
| Liquid | |
| RUO | |
| PBS with 50% glycerol and 0.05% ProClin 300; pH 7.4 | |
| Q499E0, Q76B58, Q8K1M7 | |
| 100512672, 215378, 286901, 339479 | |
| Recombinant Family With Sequence Similarity 5, Member C (FAM5C) (Arg74-Ala264). | |
| Antibody |
| 0.5 mg/mL | |
| Immunohistochemistry (Paraffin), Western Blot, Immunocytochemistry | |
| Unconjugated | |
| Rabbit | |
| Human, Mouse, Rat, Pig | |
| BRINP3 | |
| B830045N13Rik; BMP/retinoic acid inducible neural specific 3; BMP/retinoic acid-inducible neural-specific protein 3; bone morphogenetic protein/retinoic acid inducible neural specific 3; bone morphogenetic protein/retinoic acid inducible neural-specific 3; BRINP3; DBCCR1L; DBCCR1L1; DBCCR1-like protein 1; FAM5C; family with sequence similarity 5, member C; protein FAM5C; RP11-445K1.1 | |
| BRINP3 | |
| Primary | |
| Protein A |
Spécifications
| FAM5C | |
| Polyclonal | |
| Unconjugated | |
| BRINP3 | |
| B830045N13Rik; BMP/retinoic acid inducible neural specific 3; BMP/retinoic acid-inducible neural-specific protein 3; bone morphogenetic protein/retinoic acid inducible neural specific 3; bone morphogenetic protein/retinoic acid inducible neural-specific 3; BRINP3; DBCCR1L; DBCCR1L1; DBCCR1-like protein 1; FAM5C; family with sequence similarity 5, member C; protein FAM5C; RP11-445K1.1 | |
| Rabbit | |
| Protein A | |
| RUO | |
| 100512672, 215378, 286901, 339479 | |
| Store at 4°C short term. For long term storage, store at -20°C, avoiding freeze/thaw cycles. | |
| Liquid |
| Immunohistochemistry (Paraffin), Western Blot, Immunocytochemistry | |
| 0.5 mg/mL | |
| PBS with 50% glycerol and 0.05% ProClin 300; pH 7.4 | |
| Q499E0, Q76B58, Q8K1M7 | |
| BRINP3 | |
| Recombinant Family With Sequence Similarity 5, Member C (FAM5C) (Arg74-Ala264). | |
| 200 μL | |
| Primary | |
| Human, Mouse, Rat, Pig | |
| Antibody |